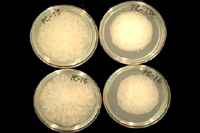

Babadoost, M. 2005. Phytophthora blight of cucurbits. The Plant Health Instructor. DOI:10.1094/PHI-I-2005-0429-01. Updated 2016.
Phytophthora blight of cucurbits
Phytophthora capsici
Cucurbits (cantaloupe, cucumber, gourd, honeydew, pumpkin, squash, watermelon), eggplant, peppers, tomatoes, and several other vegetable and weed species.

Typical symptoms of Phytophthora blight on cucurbits.
(Courtesy M. Babadoost)
Symptoms and Signs
Phytophthora blight, caused by the oomycete plant pathogen Phytophthora capsici, can develop on cucurbit plants at any stage of development (Figure 1). The pathogen can infect seedlings, vines, leaves, and fruit. The infection usually appears first in low areas of the fields where soil remains wet longer (Figure 2).
 Figure 1 |
 Figure 2 |
Damping-off. Phytophthora capsici causes pre- and post-emergence damping-off in cucurbits under wet and warm [20-30°C (68-86°F)] soil conditions. In seedlings, a watery rot develops on the hypocotyl at or near the soil line, resulting in plant death (Figure 3). Mature plants show symptoms of crown rot (Figure 4). Post-emergence plant death is preceded by plant wilting: a sudden, permanent wilt of the plant without a change in color of the foliage (Figure 5). Leaf wilting progresses from the base to the extremities of the vines. Plants often die within a few days of the first symptoms expression or after soil is saturated by excessive rain or irrigation. The stems of infected plants turn light to dark brown near the soil line and become soft and water-soaked. Infected stems collapse and die. The taproot and lateral roots of infected processing pumpkin plants usually do not exhibit symptoms. Following death of the foliage, roots may give rise to new vines if environmental conditions become less conducive for disease development. Phytophthora damping-off may result in partial to total loss of the crop.
 Figure 3 |
 Figure 4 |
 Figure 5 |
Vine blight. Vines can be affected at any time during the growing season. Water-soaked lesions develop on vines (Figure 6, see arrows). The lesions are dark olive (Figure 6-A) and then become dark brown in a few days (Figure 6-B). Lesions girdle the stem, resulting in rapid collapse and death of foliage above the lesion (Figure 6-C, D; Figure 7).
 Figure 6 |
 Figure 7 |
Leaf symptoms.Phytophthora capsici can infect both the petioles and the leaf blades of plants. Dark brown, water-soaked lesions develop on petioles (similar to lesions on vines), resulting in rapid collapse of the petiole and leaf death. Infected leaf blades develop spots ranging from 5 mm (0.2 in.) to more than 5 cm (2 in.) in diameter (Figure 8). Infected areas are chlorotic at first, but within a few days they become necrotic with chlorotic to olive-green borders. Under wet and warm conditions, leaf spots expand rapidly, coalesce, and may cover the entire leaf. Under dry conditions, leaf spots cease to expand.
 Figure 8 |
Fruit rot. Fruit rot can occur at any time from fruit set until harvest. Fruit rot generally starts on the site of the fruit that is in contact with the ground (Figure 9-B and Figure 10). However, occasionally infections will begin in other locations on the fruit where infected leaves or vines come into contact with a fruit (Figure 9-C). Also, symptoms on the upper surface of the fruit develop following rain or overhead irrigation, which can splash water containing the pathogen onto neighboring plants. Fruit rot also can develop after harvest, during transit or in storage. Fruit rot typically begins as a water-soaked lesion (Figure 9-A). Lesions expand, and become covered with white mold (Figures 9-11). The pathogen produces numerous sporangia on most infected fruit (Figures 9-11). Fruit infection progresses rapidly, resulting in complete collapse of the fruit (Figure 9-D). Phytophthora foliar blight and fruit rot may result in total loss of the crop.
 Figure 9 |
 Figure 10 |
 Figure 11 |
Pathogen Biology
Phytophthora capsici is classified in the family Pythiaceae, order Peronosporales, and class Oomycetes. Oomycetes are not true fungi and have been placed in the kingdom Stramenopila. They are more closely related to brown algae than to true fungi. The pathogen produces asexual sporangia and biflagellate zoospores and sexual oospores. Mycelia are coenocytic (non-septate).Phytophthora capsici grows at 10 to 36°C (50 to 97°F), with optimal temperatures of 24 to 33°C (75-91°F). This pathogen grows rapidly on lima bean agar (Figure 12), and the colony diameter can reach up to 8 cm (3 in.) in 5 days. The growth patterns of colonies can vary from cottony, petaloid, rosaceous, to stellate (star-shaped) (Figure 12).
Figure 12 |
Sporangia (asexual fruiting bodies) of P. capsici are produced on sporangiophores (sporangia-producing hyphae) and are mostly papillate (having a small rounded protuberance). Sporangial shapes are influenced by light and other cultural conditions, and may appear as sub-spherical, ovoid, obovoid, ellipsoid, fusiform, or pyriform. The lengths and widths of sporangia can vary from 32.8 to 65.8 and 17.4 to 38.7 μm, respectively. Length/width ratios of sporangia range from 1.3:1 to 2.1:1. Sporangia have long pedicels (stalks), ranging from 35 to 138 μm (Figure 13). Pedicellate sporangia can be dispersed in wind driven rain. Under moist conditions, zoospores (asexual spores) are produced inside sporangia. Zoospores are single-celled and biflagellate.Phytophthora capsici also produces chlamydospores (thick-walled asexual spores), which may be terminal or intercalary (between cells) on the mycelium. Chlamydospores can range in diameter from 22 to 39 μm.
 Figure 13 |
Phytophthora capsici produces sexual structures called antheridia and oogonia, and sexual spores called oospores (Figures 14 and 15). Phytophthora capsici is predominantly heterothallic with two mating types known as A1 and A2. Antheridia are amphigynous (forming a collar at the base of the oogonium after the young oogonium grows through it), with diameters of 12–21 to 12–17 μm. Oogonia are spherical or sub-spherical, with diameters ranging from 23 to 50 μm. Oospores are predominantly plerotic (filling the oogonium) with wall thicknesses ranging from 2 to 6 μm, and diameters ranging from 22 to 35 μm.
 Figure 14 |
 Figure 15 |
Phytophthora capsici is distinguished from other Phytophthora species by its sporangial morphology. Sporangia of P. capsici are caducous (easily separated from sporangiophores), have long pedicels, and are spherical to elongate with a tapering base.
Significant differences in virulence (degree of pathogenicity) and genetics among isolates of P. capsici have been reported(Figure 16). Several methods can be used to study the genetic variation of P. capsici and other fungi. Sequencing and/or restriction digest of internal transcribed spacers (ITS) regions can be used for species identification. A specific PCR primer (Pcap) has been developed that can be used with iTS primers to specifically amplify P. capsici. Inter-simple sequence repeats (ISSR) amplification, amplified fragment-length polymorphism (AFLP), allozyme genotyping, and restriction fragment length polymorphisms with a probe can be used to study genetic variation among populations of P. capsici.
 Figure 16 |
Disease Cycle and Epidemiology
Phytophthora capsici is a soilborne pathogen and survives between crops as oospores in soil or mycelium in plant debris. Oospores are resistant to desiccation, cold temperatures, and other extreme environmental conditions, and can survive in the soil, in the absence of a host plant, for several years. Oospores germinate and produce sporangia and zoospores. Zoospores are released in water and dispersed by irrigation or surface water. Zoospores are able to swim for several hours and infect plant tissues. Zoospores first lose their flagella and then encyst and form a cell wall, germinate and infect plant tissues. Abundant sporangia are produced on infected tissues, particularly on affected fruit. Sporangia are dispersed by water or in wind-driven rain in the air. Sporangia may either germinate directly and infect the host plant or germinate and give rise to zoospores that are released in water and infect the plant. The pathogen grows within the host and produces sporangia on the surface of the infected tissues. If the environmental conditions are conducive, the disease develops rapidly. Although the pathogen produces chlamydospores on culture media, their role in pathogen survival and diseases epidemiology is not known.
Soil moisture conditions are important for disease development. Sporangia form when soil pores are drained, and they release zoospores when soil is saturated (soil pores are filled with water). The disease is usually associated with heavy rainfall, excessive-irrigation, or poorly drained soil. Frequent irrigation increases the incidence of the disease. Warm conditions are favorable for disease development.
Disease Management
No single method is available to provide adequate control of Phytophthora blight. Various disease control practices can be integrated to manage Phytophthora blight, including: exclusion, cultural practices, and chemical control.
Exclusion
The most effective method of control for Phytophthora blight is to prevent P. capsici from moving into a non-infested field.Phytophthora capsici spreads by soil, water, and/or plant material. It is highly recommended to thoroughly clean all farm equipment that is used in an infested field before moving it to another field. Also, avoid using water sources (i.e. ponds or reservoirs) that receive run-off water from an infested field. Water sources can be tested for the presence of the pathogen by baiting techniques.Phytophthora capsici is not considered a seed-borne pathogen, however, saving seed from a field where Phytophthora blight occurred should be avoided.
Cultural practices
The following cultural practices can help to manage Phytophthora blight in cucurbit fields. Because P. capsici can survive in soil for several years, fields without a history of Phytophthora blight should be selected for planting. Although no cropping rotation period has been established for effective management of Phytophthora blight of cucurbits, it is recommended to select only fields that have not had a history of cucurbits, eggplant, peppers, and/or tomatoes for at least 3 years. Fields should be selected that are well isolated from fields infested with P. capsici. High soil moisture favors the development of Phytophthora blight, thus well-drained fields should be selected and excessive irrigation should be avoided. Also avoid planting cucurbit crops in areas of the field that have poor drainage.
Non-vining cucurbit crops (e.g. summer squash) should be planted on dome-shaped raised beds [approximately 25 cm (10 in. high)]. The field should be scouted regularly for Phytophthora symptoms, especially after major rainfalls, and particularly in low areas of the field. When symptoms are localized in a small area of the field, the infected plants should be plowed into the soil. Plants should be sprayed with effective fungicides at the first sign of the disease. Healthy fruit should be removed from the infested area as soon as possible, and they should be checked for disease development routinely. Growing cover crops and/or mulching with plant materials including straw and rye vetch can also be used to manage the dispersal of the pathogen.
Chemical control
Fungicide seed-treatment and spray-application can prevent seedling death and reduce foliar blight and fruit rot. Seed treatment with either mefenoxam [Apron XL LS at the rate of 0.42 ml /kg (0.64 fl oz/100 lb) seed] or metalaxyl [Allegiance FL at the rate of 0.98 ml /kg (1.5 fl oz/100 lb) seed] can protect seedlings of cucurbits against P. capsici for up to 5 weeks after planting. Spray applications of dimethomorph [Acrobat 50WP at the rate of 448 g /ha (6.4 oz/A)] plus copper sulfate [e.g. Cuprofix Disperss 36.9F at the rate of 2.25 kg/ha (2 lb/A)], at weekly intervals, can provide effective protection against foliar blight and fruit rot caused by P. capsici in cucurbit fields. Combining Apron XL LS seed-treatment with spray-applications of Acrobat plus copper can minimize crop losses to Phytophthora blight in cucurbit fields. It is important to note that resistance to both mefenoxam and metalaxyl has occurred in some areas of the US, so the sensitivity of P. capsici populations should be tested before fungicide applications are chosen.
Significance
Phytophthora blight has become one of the most serious threats to production of cucurbits and peppers worldwide.Phytophthora capsici on cucurbits was first reported in 1937 in California and Colorado. Since then, Phytophthora blight has been observed in cucurbits and peppers in most of the vegetable producing areas in the world.Phytophthora capsici commonly occurs in temperate, subtropical, and tropical environments.
Recently, the incidence of Phytophthora blight on cucurbits has dramatically increased in Illinois and other cucurbit growing areas in the world, causing up to 100% yield loss. The cucurbit industries, particularly processors, have been seriously threatened by heavy crop losses due to Phytophthora blight. For example, outbreaks of Phytophthora blight have threatened the pumpkin processing industry in Illinois, where approximately 90% of the US processed pumpkins are grown (Figure 17). Similarly, the pickling cucumber industry of Michigan also has been jeopardized due to Phytophthora blight. In addition to the food industry, cucurbits are grown for educational, recreational, and social purposes (Figure 18). Because of heavy crop losses due to Phytophthora blight, some growers have had to abandon their farms and move to different areas to find noninfested fields.
 Figure 17 |
 Figure 18 |
Because P. capsici has a wide host range, it is difficult to control Phytophthora blight. More than 50 plant species, including several weed species, in more than 15 families are hosts for P. capsici. Among the major hosts of P. capsici are red and green peppers (Capsicum annuum), watermelon (Citrullum lanatus), cantaloupe (Cucumis melo), honeydew melon (C. melo), cucumber (Cucumis sativus), blue Hubbard squash (Cucurbita maxima), acorn squash (Cucurbita moschata), gourd (C. moschata), processing pumpkin (C. moschata), yellow squash (Cucurbita pepo), zucchini squash (C. pepo), tomato (Lycopersicon esculentum), black pepper (Piper nigrum), and eggplant (Solanum melongena).
Currently, there is no single control method that is adequate to provide control of P. capsici on cucurbits. There are no cucurbit cultivars with measurable resistance to this disease. Crop rotations are virtually ineffective in controlling P. capsici because the pathogen can survive for several years in the soil, and it can infect more than 50 plant species. Outbreaks of the disease are seriously threatening the production of cucurbit crops (Figure 19). Additional research is needed to develop effective strategies for the management of Phytophthora blight on cucurbits and other vegetables.
 Figure 19 |
Selected References
Babadoost, M. and S.Z Islam. 2003. Fungicide seed treatment effects on seedling damping-off of pumpkin caused by Phytophthora capsici. Plant Dis. 87:63-68.
Erwin, D.C. and O.K. Ribeiro. 1996. Phytophthora Diseases Worldwide. American Phytopathological Society Press, St. Paul, MN.
Hausbeck, M. K., and K.H. Lamour. 2004.Phytophthora capsici on vegetable crops: Progress and challenges. Plant Dis. 88:1292-1303.
Islam, S.Z., M. Babadoost, K. Lambert, A. Ndeme, and H.M. Fouly. 2005. Characterization of Phytophthora capsici isolates from processing pumpkin in Illinois. Plant Dis. 89:191-197.
Lamour, K.H. and M.K. Hausbeck. 2000. Mefenoxam insensitivity and the sexual stage of Phytophthora capsici in Michigan cucurbit fields. Phytopathology 90:396-400.
Lee, B.K., B.S. Kim, S.W. Chang, and B.K. Hwany. 2001. Aggressiveness of isolates of Phytophthora capsici from pumpkin and pepper. Plant Dis. 85:797-800.
Leonian, L.H. 1922. Stem and fruit blight of pepper caused by Phytophthora capsici. Phytopathology 12:401-408.
Papavizas, G.S., J.H. Bowers, and S.A. Johnston. 1981. Selective isolation of Phytophthora capsici from soils. Phytopathology 71:129-133.
Ristaino, J.B. 1990. Interspecific variation among isolates of Phytophthora capsici from pepper and cucurbit fields in North Carolina. Phytopathology 80:1253-1259.
Ristaino, J. B. and S.A. Johnston. 1999. Ecologically-based approaches to management of Phytophthora blight on bell pepper. Plant Dis. 83:1080-1089.
Stamps, D.J. 1985.Phytophthora capsici. Commonw. Mycol. Inst. Descriptions of Pathogenic Fungi and Bacteria No. 836.
Stamps, D.J., G.M. Waterhouse, F.J. Newhook, and G.S. Hall. 1990. Revised tabular key to the species of Phytophthora. Commonw. Agric. Bur. Int. Mycol. Inst. Mycol. Pap. 162.
Tian, D. and M. Babadoost. 2003. Genetic variation among isolates of Phytophthora capsici from Illinois. Phytopathology 93:S84. Publication no. P-2003-0613-AMA.
Zitter, T.A., D.L. Hopkins, and C.E. Thomas. 1996. Compendium of Cucurbit Diseases. American Phytopathological Society Press, St. Paul, MN.